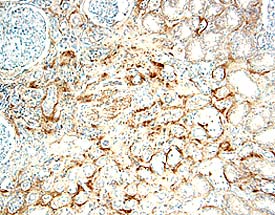
IL-17 RB antibody in Human Kidney by Immunohistochemistry (IHC-P).

Human IL-17RB Antibody
R&D Systems, part of Bio-Techne | Catalog # AF1207


Key Product Details
Species Reactivity
Validated:
Cited:
Applications
Validated:
Cited:
Label
Antibody Source
Product Specifications
Immunogen
Arg18-Gly289
Accession # NP_061195
Specificity
Clonality
Host
Isotype
Scientific Data Images for Human IL-17RB Antibody
Detection of IL‑17 RB in K562 Human Cell Line by Flow Cytometry.
K562 human chronic myelogenous leukemia cell line was stained with Goat Anti-Human IL-17 RB Antigen Affinity-purified Polyclonal Antibody (Catalog # AF1207, filled histogram) or control antibody (Catalog # AB-108-C, open histogram), followed by Phycoerythrin-conjugated Anti-Goat IgG Secondary Antibody (Catalog # F0107).IL‑17 RB in Human Kidney.
IL-17 RB was detected in immersion fixed paraffin-embedded sections of human kidney using 15 µg/mL Goat Anti-Human IL-17 RB Antigen Affinity-purified Polyclonal Antibody (Catalog # AF1207) overnight at 4 °C. Tissue was stained with the Anti-Goat HRP-DAB Cell & Tissue Staining Kit (brown; Catalog # CTS008) and counterstained with hematoxylin (blue). View our protocol for Chromogenic IHC Staining of Paraffin-embedded Tissue Sections.Applications for Human IL-17RB Antibody
CyTOF-ready
Flow Cytometry
Sample: K562 human chronic myelogenous leukemia cell line
Immunohistochemistry
Sample: Immersion fixed paraffin-embedded sections of human kidney
Western Blot
Sample: Recombinant Human IL‑17 RB Fc Chimera (Catalog # 1207-BR)
Formulation, Preparation, and Storage
Purification
Reconstitution
Formulation
Shipping
Stability & Storage
- 12 months from date of receipt, -20 to -70 °C as supplied.
- 1 month, 2 to 8 °C under sterile conditions after reconstitution.
- 6 months, -20 to -70 °C under sterile conditions after reconstitution.
Background: IL-17RB
The interleukin 17 (IL-17) family of cytokines, comprising six members (IL-17, IL-17B through IL-17F), are structurally related proteins with a conserved cysteine-knot structure. These pro-inflammatory cytokines can induce local cytokine productions and are involved in the regulation of the immune response. The cognate receptors activated by some of these cytokines have been identified (1).
Interleukin-17 B Receptor (IL-17B R), also known as IL-17Rh1, IL-17E R. and EVI27, represents the second receptor of the IL-17 family of cytokines to be recognized (2-4). Human IL-17B R cDNA encodes a 502 amino acid (aa) residue type I membrane protein with a putative 17 aa signal peptide, a 275 aa extracellular domain, a 21 aa transmembrane domain, and a 189 aa cytoplasmic tail. By alternative splicing, a secreted variant of IL-17B R has also been identified (4). Human and mouse IL‑17B R share 76% aa sequence identity. The human IL-17B R protein sequence is only 19.2% identical to the human IL-17 R sequence, but the two receptors share many conserved cysteine residues within their extracellular domains as well as additional conserved elements within their cytoplasmic domains. Three additional type I transmembrane receptors with homology to IL-17 R have been reported, increasing the number of the IL-17 R family members to five (5, 6). By Northern blot analysis, human IL-17B R is highly expressed in kidneys and liver but is expressed at lower levels in testes, brain, small intestine and other endocrine tissues (2-4). The expression of IL-17B R is significantly up-regulated under inflammatory conditions. IL-17 RB binds strongly to IL-17E and weakly to IL-17B. It does not bind IL-17, IL-17C, and IL-17F. Activation of IL-17B R by its ligands results in the activation of nuclear factor kappa-B (2-4).
References
- Aggarwal, S. and A.L. Gurney (2002) J. Leukoc. Biol. 71:1.
- Shi Y, et al. (2000) J. Biol. Chem. 275:19167.
- Lee, J, et al. (2001) J. Biol. Chem. 276:1660.
- Tian E, et al. (2000) Oncogene 19:2098.
- Haudenschild, D. et al. (2002) J. Biol. Chem. 277:4309.
- Hurst, S.D. et al. (2002) J. Immunol. 169:443.
Long Name
Alternate Names
Gene Symbol
UniProt
Additional IL-17RB Products
Product Documents for Human IL-17RB Antibody
Product Specific Notices for Human IL-17RB Antibody
For research use only